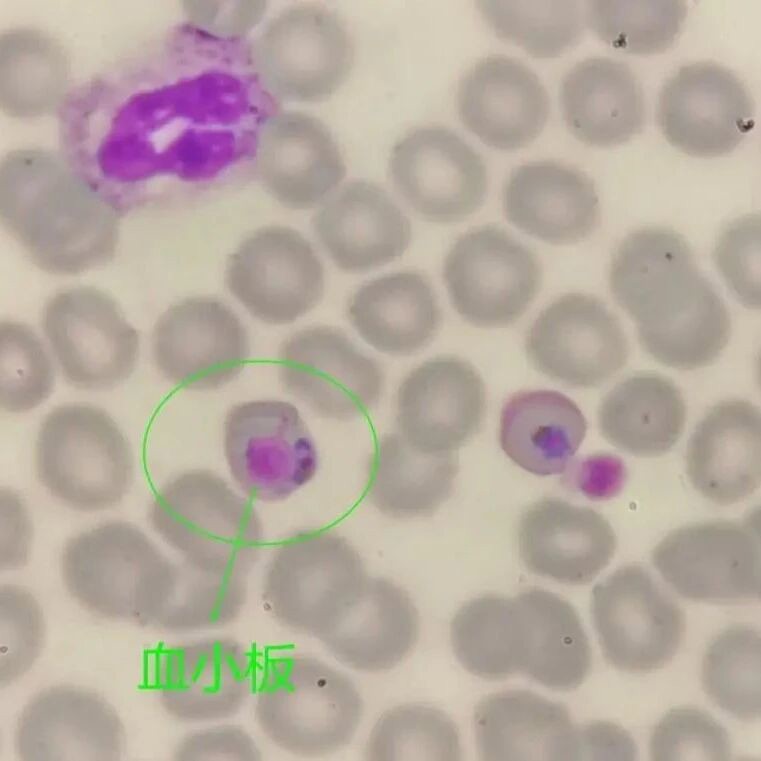
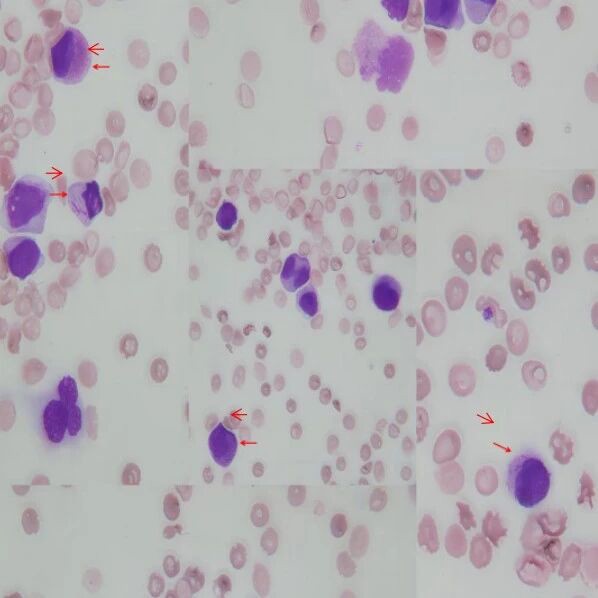

临床案例
-

一文读懂乙肝病毒双阳性的形成原因——来自“大三阳”的3+1模式解读
2025-09-11 -

跨越血型鉴定的“无效陷阱”抓出对照孔阳性的隐匿推手!
2025-09-11 -

肺鳞癌术后遭遇 “呼吸杀手”!黄曲霉感染如何被精准揪出?——多技术联用破解诊断困局
2025-09-11 -

白细胞升高别忽视!异淋揪出“幕后黑手”
2025-09-11 -

一例伦敦沙门菌引起的血流感染
2025-09-11 -
管中窥豹,一例重症疟疾带来的思考
2025-09-11 -

幼儿反复发热,背后原因竟是它?
2025-09-11 -

来自孕妇的呼救HELP、HELP、HELP!——一例HELLP综合征
2025-09-11 -
“一波未平;一波又起”
2025-09-11 -

血糖假性降低触发危急值的案例分析
2025-09-11 -

患者EBV+噬血+冠心病,医生该如何破局?
2025-09-11 -

脓毒血症的"沉默警报":当炎症因子集体飙升而白细胞沉默时
2025-09-11 -

一例Ph+急性淋巴细胞白血病的实验室诊断历程
2025-09-11 -

1例血小板增多型慢性髓细胞性白血病的诊断及文献复习
2025-09-11 -

1例XXY三倍体胎儿的产前筛查与产前诊断结果分析
2025-08-25 -

小小的脑脊液,大大的作用之捉“瘤”记
2025-08-25 -

急诊显微镜下的“抓蝴蝶”——急性早幼粒细胞白血病
2025-08-25 -

17岁男孩,HCG 阳性!
2025-08-25 -

纤毫毕现———1例抗线粒体抗体M2阳性的桥本氏甲状腺炎案例分享
2025-08-25 -

NSE阴性的“委屈”解读
2025-08-25




